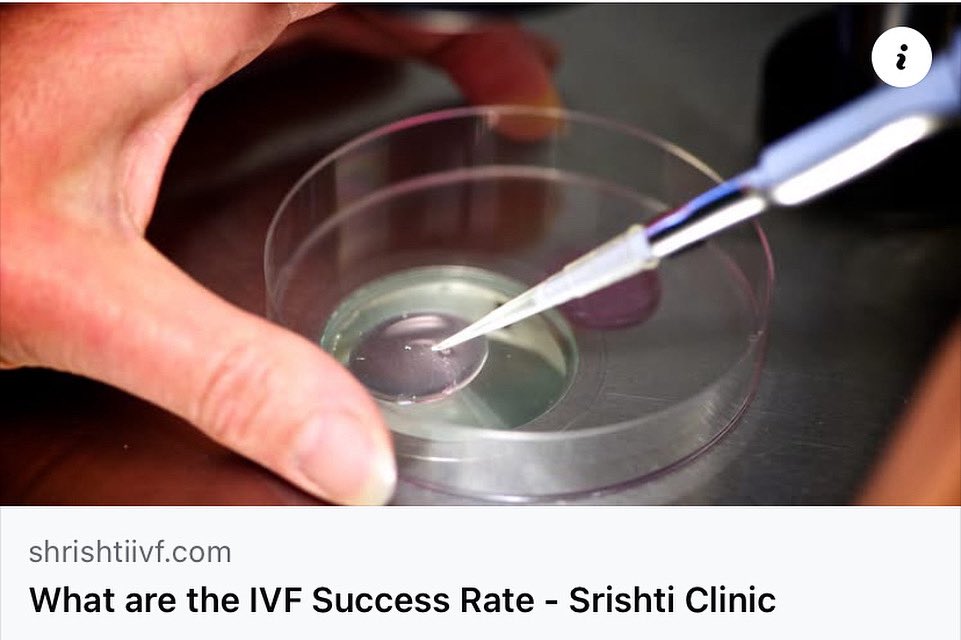
SrishtiClinic's tweet image. #BlogAlert Understanding the IVF success rate in India from Srishti IVF Clinic, Kolkata 
Please share the blog with the ones in need. 📖

#ivfsuccess #success

#blogalert 검색 결과
📌#BlogAlert Read Ishita Narvekar’s “Reshaping Indian MSMEs with Local Wisdom” in this week’s blog! Link: buff.ly/qSwRLTy 💛 Support independent academic research in India! 🔖 Donate now: buff.ly/e3QVJyV

📜 #BlogAlert | 𝗧𝗮𝗺𝗶𝗹 𝗡𝗮𝗱𝘂’𝘀 𝗢𝗻𝗹𝗶𝗻𝗲 𝗚𝗮𝗺𝗶𝗻𝗴 𝗥𝗲𝗴𝘂𝗹𝗮𝘁𝗶𝗼𝗻𝘀: 𝗔 𝗡𝗲𝗰𝗲𝘀𝘀𝗮𝗿𝘆 𝗦𝗮𝗳𝗲𝗴𝘂𝗮𝗿𝗱 𝗼𝗿 𝗮 𝗖𝗵𝗮𝗹𝗹𝗲𝗻𝗴𝗶𝗻𝗴 𝗠𝗮𝗻𝗱𝗮𝘁𝗲? 𝙸𝚖𝚊𝚐𝚒𝚗𝚎 𝚕𝚘𝚐𝚐𝚒𝚗𝚐 𝚒𝚗𝚝𝚘 𝚢𝚘𝚞𝚛 𝚏𝚊𝚟𝚘𝚞𝚛𝚒𝚝𝚎 𝚐𝚊𝚖𝚎—𝚘𝚗𝚕𝚢 𝚝𝚘 𝚋𝚎 𝚖𝚎𝚝…

📌#BlogAlert Read Ananya Gaunekar's “The Double Stitch: How Sweatshops Hurt and Help” in this week’s blog! Link: buff.ly/Ht0yEFL 💛 Support independent academic research in India! 🔖 Donate now: buff.ly/e3QVJyV

#BlogAlert India’s #pharma & #medtech sector is evolving from generics to innovation with the Promotion of Research and Innovation in Pharma MedTech (#PRIP) scheme, boosting R&D and global #investment. Discover India's rise in healthcare: tinyurl.com/blogs-PRIP-Sch… #InvestInIndia

#BlogAlert With a rapidly growing workforce and an evolving talent ecosystem, #NewIndia offers unmatched talent power, skill and agility, empowering businesses to grow & compete globally. Read more: tinyurl.com/blogs-Indias-L… #InvestInIndia #JobGrowth #YoungIndia #FemaleWorkforce

#BlogAlert #NewIndia’s #biotechhubs are driving global #innovation, from vaccines to healthtech, offering investors the perfect mix of talent, tech and growth. Tap into India’s #biotech hotspots: tinyurl.com/Blogs-Top-Five… @makeinindia

📌#BlogAlert Read Alifa Vakil's “Why We Crave Closure” in this week’s blog! Link: buff.ly/a13vs2H 💛 Support independent academic research in India! Your donations are now eligible for 50% tax exemption under section 80G. 🔖 Donate now: buff.ly/e3QVJyV

#BlogAlert #GST rationalisation anchors a new era of transparency for global businesses. This structural reform, alongside #PLI-linked #industrialisation, secures India's place as a manufacturing powerhouse. Read more: tinyurl.com/blogs-NEXT-GEN… #InvestInIndia #NextGenGST

📌#BlogAlert Read Rujula Joshi's “The Bleeding Economy: When Periods Cost Trillions” in this week’s blog! Link: buff.ly/XNoXcRS 💛 Support independent academic research in India! 🔖 Donate now: buff.ly/e3QVJyV

#BlogAlert #NewIndia’s capital goods sector is fuelling the #MakeInIndia vision, driving manufacturing growth, innovation & exports, strengthening its position as a global industrial powerhouse. Read more about India’s growth engine: tinyurl.com/II-Blogs-Capit… @makeinindia

#BlogAlert Discover the six factors powering the future of defence. From smart drones and #AI-driven warfare to space systems and thriving #MSMEs, India’s #defence tech boom is redefining global strategy. Read more: tinyurl.com/blogs-Indias-D… #InvestInIndia #AatmanirbharBharat

📌#BlogAlert Read Sharmila Bommadevara’s “Credit Where It’s Due: Caste Bias in Microfinance Institutions” in this week’s blog! Link: buff.ly/scmjXNq 💛 Support independent academic research in India! 🔖 Donate now: buff.ly/e3QVJyV

#BlogAlert Check out Dr. Cameka Smith @iamcameka discuss supporting Black women entrepreneurs and how you can BOSS up via @hopemag hopeforwomenmag.com/hope-for-women…

Don’t just scroll — start earning! Check out our blog post on how to make $$$ with exclusive content on Alua. 💸 #BlogAlert alua.com/blog/how-to-ma…
📜 #BlogAlert #SPAMalert 𝗦𝗽𝗮𝗺 𝗰𝗮𝗹𝗹𝘀. 𝗣𝗵𝗶𝘀𝗵𝗶𝗻𝗴 𝗹𝗶𝗻𝗸𝘀. 𝗨𝗻𝘄𝗮𝗻𝘁𝗲𝗱 𝗽𝗿𝗼𝗺𝗼𝘁𝗶𝗼𝗻𝘀. If you've ever wondered why your phone keeps buzzing with messages you never asked for — you’re not alone. With 𝗼𝘃𝗲𝗿 𝟭𝟮 𝗺𝗶𝗹𝗹𝗶𝗼𝗻 𝗰𝗼𝗺𝗽𝗹𝗮𝗶𝗻𝘁𝘀…

#BlogAlert Want to know why the world is watching India’s exports? Make in India is transforming industries, driving growth and positioning India as a key global trade leader. Read more about the #MakeInIndia impact: tinyurl.com/II-Blogs-India… #InvestInIndia #Innovation #Textiles

📜#BlogAlert! #EventRecap 𝗘𝗺𝗽𝗼𝘄𝗲𝗿𝗶𝗻𝗴 𝗪𝗼𝗺𝗲𝗻 - 𝗛𝗮𝗿𝗻𝗲𝘀𝘀𝗶𝗻𝗴 𝗔𝗜 𝗳𝗼𝗿 𝗦𝗼𝗰𝗶𝗮𝗹 𝗣𝗿𝗼𝗴𝗿𝗲𝘀𝘀 The Dialogue recently hosted "Empowering Women: Harnessing AI for Social Progress," an illuminating fireside chat and panel discussion on the…

#BlogAlert Understanding the IVF success rate in India from Srishti IVF Clinic, Kolkata Please share the blog with the ones in need. 📖 #ivfsuccess #success
#Womenwithdisabilities in Mizoram face poverty, low education, stigma, and lack of aids. Family, faith, and community provide strength. The book offers policy solutions for inclusion. This blog features an exclusive excerpt. tinyurl.com/46vj8znf #blogalert #Vivabooks
#BlogAlert #NewIndia’s #biotechhubs are driving global #innovation, from vaccines to healthtech, offering investors the perfect mix of talent, tech and growth. Tap into India’s #biotech hotspots: tinyurl.com/Blogs-Top-Five… @makeinindia

#BlogAlert 📣 The holiday season is approaching, bringing excitement, planning, shopping, and sometimes overwhelming feelings. Many days blur together as we rush from one responsibility to the next. talentremedy.com/post/how-grati… #ExecutiveSearch #OutsourcedRecruiting

📌 #BlogAlert Read Sameer Chawla’s “The Kaveri Engine Saga” in this week’s blog! Link: buff.ly/P7ikoFW 💛 Support independent academic research in India! Your donations are now eligible for 50% tax exemption under section 80G. 🔖 Donate now: buff.ly/e3QVJyV

#BlogAlert 📣 Many companies hit pause on hiring when the holidays roll around, assuming that November and December are too busy or too slow to attract good candidates. Click to continue reading this week's blog! talentremedy.com/post/hiring-du… #ExecutiveSearch #OutsourcedRecruiting

#BlogAlert Backed by policy momentum, capital inflows & an evolving industrial base, India’s non-leather footwear industry is gearing up for global leadership. Read more to explore the shift towards sustainable footwear: tinyurl.com/blogs-Non-Leat… #InvestInIndia #IndiaOpportunity

📌#BlogAlert Read Ishita Narvekar’s “Reshaping Indian MSMEs with Local Wisdom” in this week’s blog! Link: buff.ly/qSwRLTy 💛 Support independent academic research in India! 🔖 Donate now: buff.ly/e3QVJyV

Davin's latest blog is online. He discusses the FBI agents that were recently fired for taking a knee during the George Floyd protests in 2020. Read it here: davincomedy.com/your-services-… We discuss Saturday @talkmedianetwrk and the podcast drops Sunday. #blog #blogger #blogpost

Big changes are coming to DFW’s digital backbone! Discover how the latest network upgrades will supercharge speed and reliability across the Metroplex. Don’t miss out, read the full story here: hubs.li/Q03ThkX80 #Dallas #BlogAlert #November #FridayReads
#BlogAlert #KoreanIPOs in India, such as @HyundaiIndia and @LGIndia, showcase growing trust in India’s capital market. Let's examine why Korean companies are investing heavily in India's long-term potential. Explore more here: tinyurl.com/blogs-Korean-I… #InvestInIndia

📌#BlogAlert Read Ananya Gaunekar's “The Double Stitch: How Sweatshops Hurt and Help” in this week’s blog! Link: buff.ly/Ht0yEFL 💛 Support independent academic research in India! 🔖 Donate now: buff.ly/e3QVJyV

🚨 #BlogAlert! Why should Small & Medium #Businesses in #Singapore consider #PayrollServices? 💼 Outsourcing #payroll helps save time, cut costs, and ensure compliance — letting you focus on growing your business! 👉 Blog Link: syngrid.com/global-payroll…

📌#BlogAlert Read Rujula Joshi's “The Bleeding Economy: When Periods Cost Trillions” in this week’s blog! Link: buff.ly/XNoXcRS 💛 Support independent academic research in India! 🔖 Donate now: buff.ly/e3QVJyV

#BlogAlert #NewIndia’s capital goods sector is fuelling the #MakeInIndia vision, driving manufacturing growth, innovation & exports, strengthening its position as a global industrial powerhouse. Read more about India’s growth engine: tinyurl.com/II-Blogs-Capit… @makeinindia

#BlogAlert 🤝 Are you choosing the right stakeholder engagement software? Discover the key features, user experiences, and what truly sets Jambo apart in stakeholder relationship management. If you’re looking for transparency, efficiency, and ease of use for your next project,…

#BlogAlert With a rapidly growing workforce and an evolving talent ecosystem, #NewIndia offers unmatched talent power, skill and agility, empowering businesses to grow & compete globally. Read more: tinyurl.com/blogs-Indias-L… #InvestInIndia #JobGrowth #YoungIndia #FemaleWorkforce

📜 #BlogAlert | 𝗧𝗮𝗺𝗶𝗹 𝗡𝗮𝗱𝘂’𝘀 𝗢𝗻𝗹𝗶𝗻𝗲 𝗚𝗮𝗺𝗶𝗻𝗴 𝗥𝗲𝗴𝘂𝗹𝗮𝘁𝗶𝗼𝗻𝘀: 𝗔 𝗡𝗲𝗰𝗲𝘀𝘀𝗮𝗿𝘆 𝗦𝗮𝗳𝗲𝗴𝘂𝗮𝗿𝗱 𝗼𝗿 𝗮 𝗖𝗵𝗮𝗹𝗹𝗲𝗻𝗴𝗶𝗻𝗴 𝗠𝗮𝗻𝗱𝗮𝘁𝗲? 𝙸𝚖𝚊𝚐𝚒𝚗𝚎 𝚕𝚘𝚐𝚐𝚒𝚗𝚐 𝚒𝚗𝚝𝚘 𝚢𝚘𝚞𝚛 𝚏𝚊𝚟𝚘𝚞𝚛𝚒𝚝𝚎 𝚐𝚊𝚖𝚎—𝚘𝚗𝚕𝚢 𝚝𝚘 𝚋𝚎 𝚖𝚎𝚝…

📌#BlogAlert Read Ishita Narvekar’s “Reshaping Indian MSMEs with Local Wisdom” in this week’s blog! Link: buff.ly/qSwRLTy 💛 Support independent academic research in India! 🔖 Donate now: buff.ly/e3QVJyV

Unlock the Power of Reputation Management 🚀📚📈 Dive into our latest blog where we break down the ABCs of brand reputation management! 🌟 Learn more topworkplaces.com/company-reputa… #BrandReputationMatters #BlogAlert #DigitalStrategy

#BlogAlert as a beautiful coincidence...today our Blog team release the @patricia_boya interview as she is our Keynote Speaker from this year Annual Symposium...don't miss a bit!! #SheIsAmazing #SheRocks womeninautophagy.com/post/interview…

#BlogAlert have you read our last Blog entry? Yes...it's true...we have Prof. Yoshinori Ohsumi explaining about his research...#DoNOTmissIT #NobelPrize @NobelPrize ⬇️⬇️⬇️here more: womeninautophagy.com/post/interview… @SEBBM_es @SEFAGIA_ @FEBSnews @NatureCellBio @NatureAging

#BlogAlert #DidYouKnow: Over the past 7 years, @MORTHIndia has paved the way for progress in the North-East region, completing an impressive 4100+ km of road projects. Explore investment opportunities in the sector at bit.ly/41786tq

#BlogAlert #GST rationalisation anchors a new era of transparency for global businesses. This structural reform, alongside #PLI-linked #industrialisation, secures India's place as a manufacturing powerhouse. Read more: tinyurl.com/blogs-NEXT-GEN… #InvestInIndia #NextGenGST

#BlogAlert India’s #pharma & #medtech sector is evolving from generics to innovation with the Promotion of Research and Innovation in Pharma MedTech (#PRIP) scheme, boosting R&D and global #investment. Discover India's rise in healthcare: tinyurl.com/blogs-PRIP-Sch… #InvestInIndia

📌#BlogAlert Read Ayushi Bhandari’s “To Be Seen is to Be Cared for, and To Be Cared for is To Be Documented” in this week’s blog! Link: buff.ly/2vfK1qx 💛 Support independent academic research in India! 🔖 Donate now: buff.ly/e3QVJyV

#BlogAlert Check out Dr. Cameka Smith @iamcameka discuss supporting Black women entrepreneurs and how you can BOSS up via @hopemag hopeforwomenmag.com/hope-for-women…

#BlogAlert #DidYouKnow: #NewIndia set an ambitious target to achieve net zero emissions by 2070 and generate 50% of its electricity from renewable sources by 2030. Read more: bit.ly/44aezp0 @mnreindia

📜 #BlogAlert #SPAMalert 𝗦𝗽𝗮𝗺 𝗰𝗮𝗹𝗹𝘀. 𝗣𝗵𝗶𝘀𝗵𝗶𝗻𝗴 𝗹𝗶𝗻𝗸𝘀. 𝗨𝗻𝘄𝗮𝗻𝘁𝗲𝗱 𝗽𝗿𝗼𝗺𝗼𝘁𝗶𝗼𝗻𝘀. If you've ever wondered why your phone keeps buzzing with messages you never asked for — you’re not alone. With 𝗼𝘃𝗲𝗿 𝟭𝟮 𝗺𝗶𝗹𝗹𝗶𝗼𝗻 𝗰𝗼𝗺𝗽𝗹𝗮𝗶𝗻𝘁𝘀…

#BlogAlert: A Legacy of Learning We are excited to share a new blog written by Akkamahadevi Melligeri, Chairperson of Aequs Foundation, about the Anasuya Melligeri Science and Technology Center. This centre empowers young minds through hands-on STEAM education. Each year, we…

📜#BlogAlert! #EventRecap 𝗘𝗺𝗽𝗼𝘄𝗲𝗿𝗶𝗻𝗴 𝗪𝗼𝗺𝗲𝗻 - 𝗛𝗮𝗿𝗻𝗲𝘀𝘀𝗶𝗻𝗴 𝗔𝗜 𝗳𝗼𝗿 𝗦𝗼𝗰𝗶𝗮𝗹 𝗣𝗿𝗼𝗴𝗿𝗲𝘀𝘀 The Dialogue recently hosted "Empowering Women: Harnessing AI for Social Progress," an illuminating fireside chat and panel discussion on the…

#BLOGALERT Calculating the Return on Investment (ROI) of talent acquisition is crucial for showing its value beyond just filling a role. It helps justify budgets and proves that a great hire is a profit driver, not just an expense. 💰 Read it here: stahlrecruiting.com/post/the-roi-o…

#BlogAlert We are excited to share a new blog post from Mai Melligeri, Chairperson of Aequs Foundation. Dive into her inspiring journey with the foundation and learn about our impactful initiatives in STEAM education, health, and community empowerment. Discover how we're…

#BlogAlert Discover the six factors powering the future of defence. From smart drones and #AI-driven warfare to space systems and thriving #MSMEs, India’s #defence tech boom is redefining global strategy. Read more: tinyurl.com/blogs-Indias-D… #InvestInIndia #AatmanirbharBharat

📌#BlogAlert Read Sharmila Bommadevara’s “Credit Where It’s Due: Caste Bias in Microfinance Institutions” in this week’s blog! Link: buff.ly/scmjXNq 💛 Support independent academic research in India! 🔖 Donate now: buff.ly/e3QVJyV

📜 #BlogAlert #IWD2024 Dive into the deep insights from our colleague, Shruti Shreya (Senior Programme Manager - Platform Regulation, Gender and Tech), as she unravels the complexities of deepfakes in today's digital landscape. This International Women's Day, Shruti explores the…

📌#BlogAlert Read Ananya Gaunekar's “The Double Stitch: How Sweatshops Hurt and Help” in this week’s blog! Link: buff.ly/Ht0yEFL 💛 Support independent academic research in India! 🔖 Donate now: buff.ly/e3QVJyV

Something went wrong.
Something went wrong.
United States Trends
- 1. Texas 156K posts
- 2. 3-8 Florida 2,084 posts
- 3. #JimmySeaFanconD1 251K posts
- 4. #HookEm 10.6K posts
- 5. Austin Reaves 12.5K posts
- 6. Sark 5,128 posts
- 7. Jeff Sims 1,674 posts
- 8. Aggies 9,324 posts
- 9. Arch 25.4K posts
- 10. #DonCheadleDay 1,201 posts
- 11. Georgia 49.5K posts
- 12. Arizona 32.5K posts
- 13. Life is 10% 2,658 posts
- 14. #LakeShow 3,632 posts
- 15. Marcel Reed 4,462 posts
- 16. Elko 3,028 posts
- 17. Katie Miller 2,484 posts
- 18. Banana Fish 9,629 posts
- 19. SEC Championship 5,285 posts
- 20. Sylus 94.4K posts


























